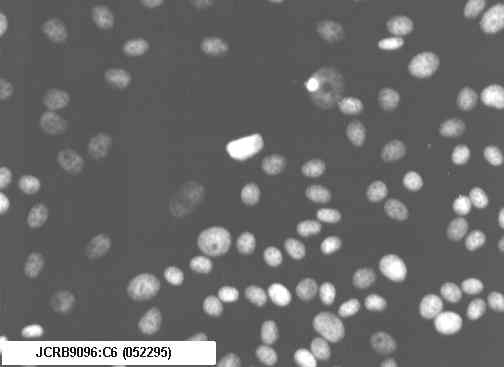

JCRB9096 C6 Cell information
Cell type:general cells
(View Pricing Information )
JCRB No.
JCRB9096
Cell Name
C6
Profile
glial tumor, GFAP-positive
Other Name
Animal
rat
Strain
Genus
Rattus
Species
norvegicus
Sex
Age
Identity
Tissue for Primary Cancer
neural
Case history
Metastasis
Tissue Metastasized
Genetics
glial cell tumor
Life Span
Crisis PDL
Morphology
Character
glial cell tumor
Classify
Established by
Benda,P. et al.
Registered by
Regulation for Distribution
Comment
Prepared from CCL 107.
Year
1986
Medium
Ham's F10 medium 82.5% with 15% horse serum and 2.5% fetal calf serum.
Methods for Passages
Cells are treated with 0.02% EDTA and 0.25% trypsin
Cell Number on Passage
1/2 - 1/3
Race
CO2 Conc.
5 %
Tissue Sampling
brain
Tissue Type
Detection of virus genome fragment by Real-time PCR
Detected DNA Virus
not tested
Detected RNA Virus
not tested
Reference
Pubmed id:4873531 Differentiated rat glial cell strain in tissue culture.
Movies
LOT Information
Viability/Growth rate/Cell number are represented as actual values measured at lot presentation in JCRB, but are not guaranteed values. Additionally, the doubling time is a rough value measured during passages.
Cell No.
JCRB9096
Cell Name
C6
LOT No.
031596
Lot Specification
distribution
Medium
Ham's F10 with 15% horse serum (lot;ICN Flow 2070033) and 2.5% fetal calf serum (lot;JRS CO19407)
Temperature
37 C
Cell Density at Seeding
1-2 x 10^5 cells/ml
Methods for Passages
Wash with PBS(-), and treat with 0.25% trypsin and0.02% EDTA for 5 min at 37 C.
Doubling Time
Cell Number in Vial (cells/1ml)
1.5 x 10^6
Viability at cell freezing (%)
97
Antibiotics Used
free
Passage Number
P44
PDL
Sterility: MYCOPLASMA
-
Sterility: BACTERIA
-
Sterility: FUNGI
-
Isozyme Analysis
Chromosome Mode
Chromosome Information
Surface Antigen
DNA Profile (STR)
Adhesion
Yes
Exoteric Gene
Medium for Freezing
CO2 Conc.
5%
Viability immediately after thawing (%)
Additional information
Cell No.
JCRB9096
Cell Name
C6
LOT No.
052295
Lot Specification
distribution
Medium
HamF10 with 15% horse serum (ICN Flow 2070033) and 2.5% fetal bovine serum (ICN Flow 101083)
Temperature
37 C
Cell Density at Seeding
1.0x10^6 cells/dish
Methods for Passages
Wash cells with PBS(-) twice and treated with 0.25% trypsin and 0.02% EDTA for 3 min. at room tmp.
Doubling Time
16.2 hr
Cell Number in Vial (cells/1ml)
1.11x10^6
Viability at cell freezing (%)
98.0
Antibiotics Used
free
Passage Number
P43
PDL
NT
Sterility: MYCOPLASMA
-
Sterility: BACTERIA
NT
Sterility: FUNGI
NT
Isozyme Analysis
G6PD,LDH,NP
Chromosome Mode
NT
Chromosome Information
NT
Surface Antigen
NT
DNA Profile (STR)
Adhesion
Yes
Exoteric Gene
NT
Medium for Freezing
CO2 Conc.
Viability immediately after thawing (%)
Additional information
Cell No.
JCRB9096
Cell Name
C6
LOT No.
011193
Lot Specification
distribution
Medium
Ham's F10 medium (Gibco) with 15% horse serum (ICNFlow 0130293) and 2.5% FBS (Flow, 0070893)
Temperature
37 C
Cell Density at Seeding
1.2x10^5cells/ml
Methods for Passages
Cells are washed once with PBS(-) and treated with0.25% trypsin and 0.02% EDTA for 3min at room tmp.
Doubling Time
12-24 hr.
Cell Number in Vial (cells/1ml)
1.98x10^6
Viability at cell freezing (%)
98%
Antibiotics Used
free
Passage Number
P44
PDL
NT
Sterility: MYCOPLASMA
-
Sterility: BACTERIA
-
Sterility: FUNGI
-
Isozyme Analysis
G6PD,NP
Chromosome Mode
NT
Chromosome Information
NT
Surface Antigen
NT
DNA Profile (STR)
Adhesion
Yes
Exoteric Gene
NT
Medium for Freezing
CO2 Conc.
Viability immediately after thawing (%)
Additional information
Cell No.
JCRB9096
Cell Name
C6
LOT No.
040689
Lot Specification
distribution
Medium
Ham's F10, 82.5% + horse serum, 15% + FCS, 2.5%
Temperature
37
Cell Density at Seeding
1/2 - 1/3
Methods for Passages
0.02% EDTA and 0.25% trypsin.
Doubling Time
NT
Cell Number in Vial (cells/1ml)
5.8x10^6
Viability at cell freezing (%)
NT
Antibiotics Used
free
Passage Number
P44
PDL
Sterility: MYCOPLASMA
-
Sterility: BACTERIA
-
Sterility: FUNGI
-
Isozyme Analysis
NT
Chromosome Mode
Chromosome Information
NT
Surface Antigen
DNA Profile (STR)
Adhesion
Exoteric Gene
Medium for Freezing
CO2 Conc.
Viability immediately after thawing (%)
Additional information
Cell No.
JCRB9096
Cell Name
LOT No.
09112000
Lot Specification
distribution
Medium
Ham's F10 medium with 15% horse serum and 2.5% fetal calf serum
Temperature
37 C
Cell Density at Seeding
3-6 x 10^4 cells/ml
Methods for Passages
0.25% trypsin and 0.02% EDTA
Doubling Time
D.T. = 26-29 hrs
Cell Number in Vial (cells/1ml)
4.0 x 10^6
Viability at cell freezing (%)
98
Antibiotics Used
free
Passage Number
P45
PDL
Sterility: MYCOPLASMA
-
Sterility: BACTERIA
-
Sterility: FUNGI
-
Isozyme Analysis
Confirmed as rat by NP, G6PD, MD.
Chromosome Mode
Chromosome Information
Surface Antigen
DNA Profile (STR)
Adhesion
Exoteric Gene
Medium for Freezing
CO2 Conc.
Viability immediately after thawing (%)
Additional information
Cell No.
JCRB9096
Cell Name
C6
LOT No.
10102014
Lot Specification
distribution
Medium
Ham's F10 medium with 15% horse serum and 2.5% fetal bovine serum
Temperature
37 C
Cell Density at Seeding
1.0 - 1.7 x 10^5 cells/mL
Methods for Passages
Cells were harvested after treatment with 0.25% trypsin and 0.02% EDTA.
Doubling Time
approx. 19 hrs
Cell Number in Vial (cells/1ml)
1.9 x 10^6
Viability at cell freezing (%)
75.8
Antibiotics Used
free
Passage Number
P43
PDL
Sterility: MYCOPLASMA
-
Sterility: BACTERIA
-
Sterility: FUNGI
-
Isozyme Analysis
Confirmed as rat by NP, G6PD, MD.
Chromosome Mode
Chromosome Information
Surface Antigen
DNA Profile (STR)
Adhesion
Yes
Exoteric Gene
Medium for Freezing
10% DMSO in culture medium
CO2 Conc.
5%
Viability immediately after thawing (%)
75.8
Additional information